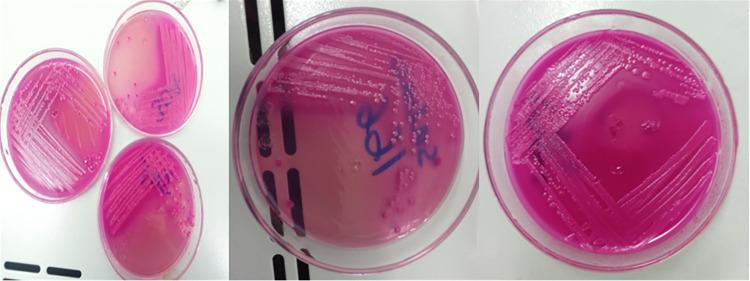
https://cdn.ncbi.nlm.nih.gov/pmc/blobs/aa0a/9882751/78b008dccb51/pntd.0010706.g002.jpg
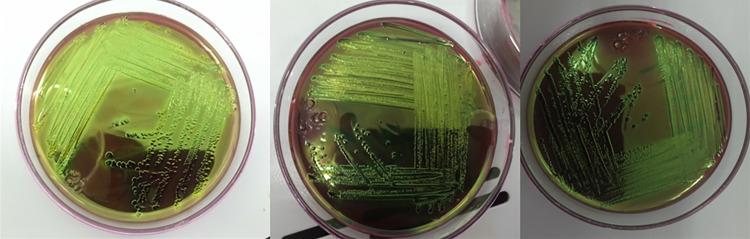
https://cdn.ncbi.nlm.nih.gov/pmc/blobs/aa0a/9882751/876035cfb29d/pntd.0010706.g003.jpg

埃塞俄比亚德西和孔博恰镇牛源食品中产 O157:H7 型大肠杆菌的发生情况及其耐药模式。
Occurrence and antimicrobial resistance pattern of E. coli O157:H7 isolated from foods of Bovine origin in Dessie and Kombolcha towns, Ethiopia.
机构信息
School of Veterinary Medicine, Wollo University, Dessie, Ethiopia.
Institute of Biotechnology, Addis Ababa University, Addis Ababa, Ethiopia.
出版信息
PLoS Negl Trop Dis. 2023 Jan 27;17(1):e0010706. doi: 10.1371/journal.pntd.0010706. eCollection 2023 Jan.
E. coli are frequently isolated food-borne pathogens from meat, milk, and their products. Moreover, there has been a significant rise in the antimicrobial resistance patterns of E. coli O157:H7 to commonly used antibiotics. A cross-sectional study was conducted from October 2019 to July 2021 to estimate prevalence and identify associated factors of E. coli and E. coli O157:H7 and to determine antibiotic resistance pattern of E. coli O157:H7 from foods of bovine origin in Dessie and Kombolcha towns. A total of 384 samples were collected. Systematic and simple random sampling techniques were employed for sampling carcasses and milking cows, respectively. E. coli and E. coli O157:H7 were detected according to recommended bacteriological protocols. E. coli O157:H7 strains were evaluated for in vitro antimicrobial susceptibility using agar disk diffusion method. Both descriptive and inferential statistical techniques were applied to analyze the data. Overall prevalence rates of E. coli and E. coli O157:H7 were 54.7% and 6.5%, respectively. Highest prevalence rates of E. coli (79.6%) and E. coli O157:H7 (16.7%) were obtained from carcass swabs and milk tank samples, respectively. Unlike E. coli O157:H7, a statistically significant difference in the E. coli prevalence (P<0.05) was observed among the different sample types. Multidrug resistance was observed among all isolates of E. coli O157:H7. All E. coli O157:H7 isolates (100.0%) were susceptible to Ampicillin, Sulfamethoxazole-trimethoprim, and Norfloxacin. On the contrary, all of the isolates (100%) were resistant to Penicillin G, Vancomycin, and Oxacillin. The current study indicated that different foods of bovine origin in the study area were unsafe for human consumption. Hence, good hygienic production methods should be employed to ensure the safety of foods of bovine origin.
大肠杆菌是从肉类、牛奶及其制品中经常分离出的食源性致病菌。此外,大肠杆菌 O157:H7 对抗生素的耐药模式有显著上升。本研究于 2019 年 10 月至 2021 年 7 月进行了一项横断面研究,旨在评估埃塞俄比亚德西和孔波查镇牛源食品中大肠杆菌和大肠杆菌 O157:H7 的流行率和相关因素,并确定大肠杆菌 O157:H7 的抗生素耐药模式。共采集 384 份样本。分别采用系统抽样和简单随机抽样技术采集胴体和奶牛奶样。根据推荐的细菌学方案检测大肠杆菌和大肠杆菌 O157:H7。采用琼脂扩散法评估大肠杆菌 O157:H7 菌株的体外抗菌药敏性。采用描述性和推断性统计技术对数据进行分析。大肠杆菌和大肠杆菌 O157:H7 的总流行率分别为 54.7%和 6.5%。大肠杆菌(79.6%)和大肠杆菌 O157:H7(16.7%)的最高流行率分别来自胴体拭子和奶罐样本。与大肠杆菌 O157:H7 不同,不同样本类型的大肠杆菌流行率(P<0.05)存在统计学差异。所有大肠杆菌 O157:H7 分离株均表现出多药耐药性。所有大肠杆菌 O157:H7 分离株(100.0%)对氨苄西林、磺胺甲噁唑-甲氧苄啶和诺氟沙星敏感。相反,所有分离株(100%)对青霉素 G、万古霉素和苯唑西林均耐药。本研究表明,研究区不同的牛源食品对人类食用不安全。因此,应采用良好的卫生生产方法,确保牛源食品的安全。